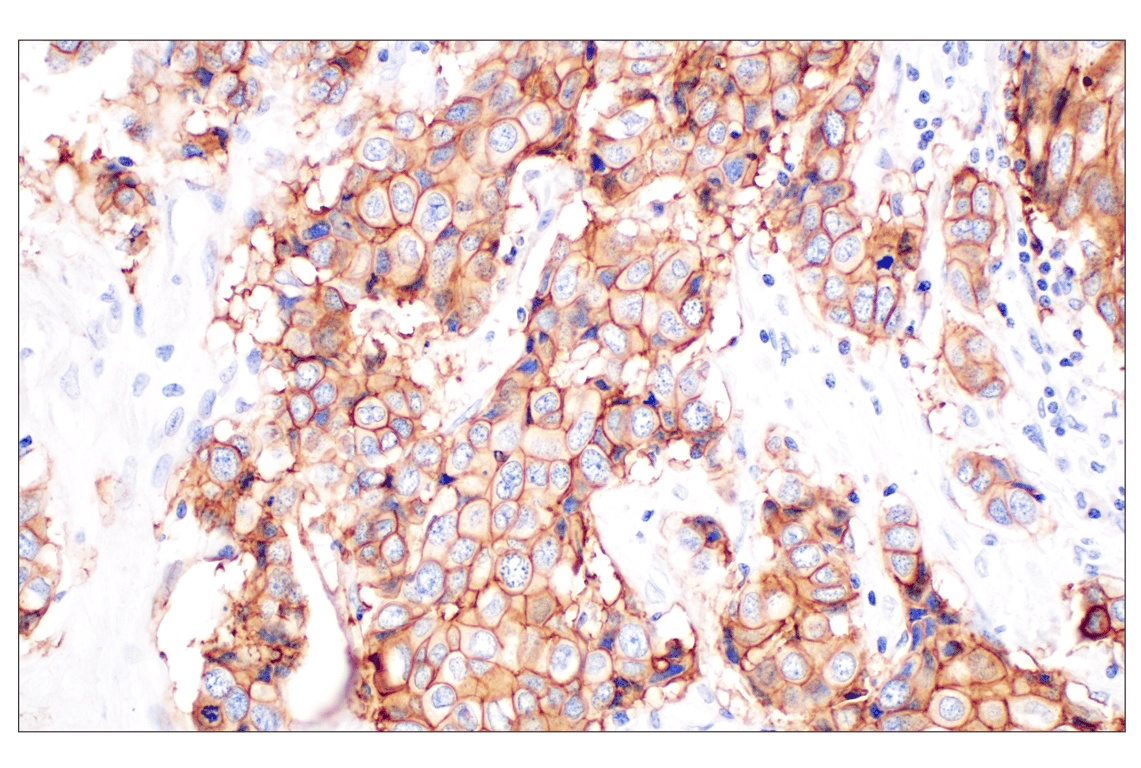
Immunohistochemistry Image 2: TACSTD2/TROP2 (F4W4J) Rabbit Monoclonal Antibody (BSA and Azide Free)
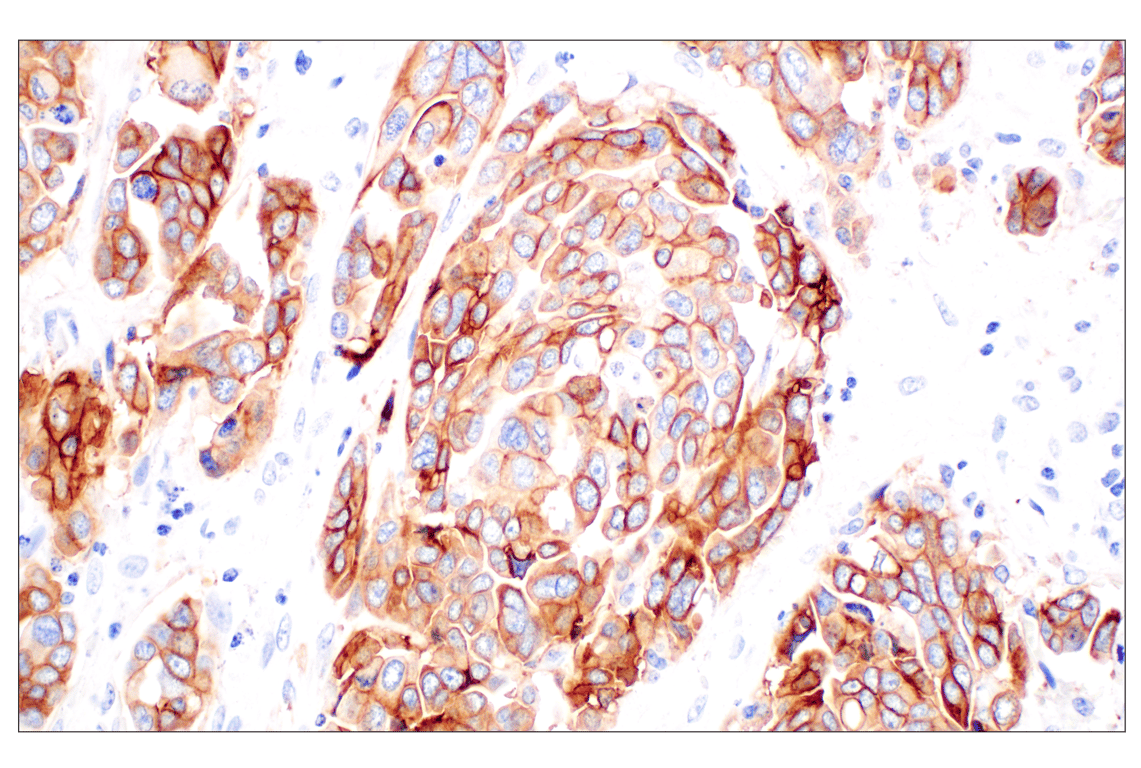
Immunohistochemistry Image 4: TACSTD2/TROP2 (F4W4J) Rabbit Monoclonal Antibody (BSA and Azide Free)
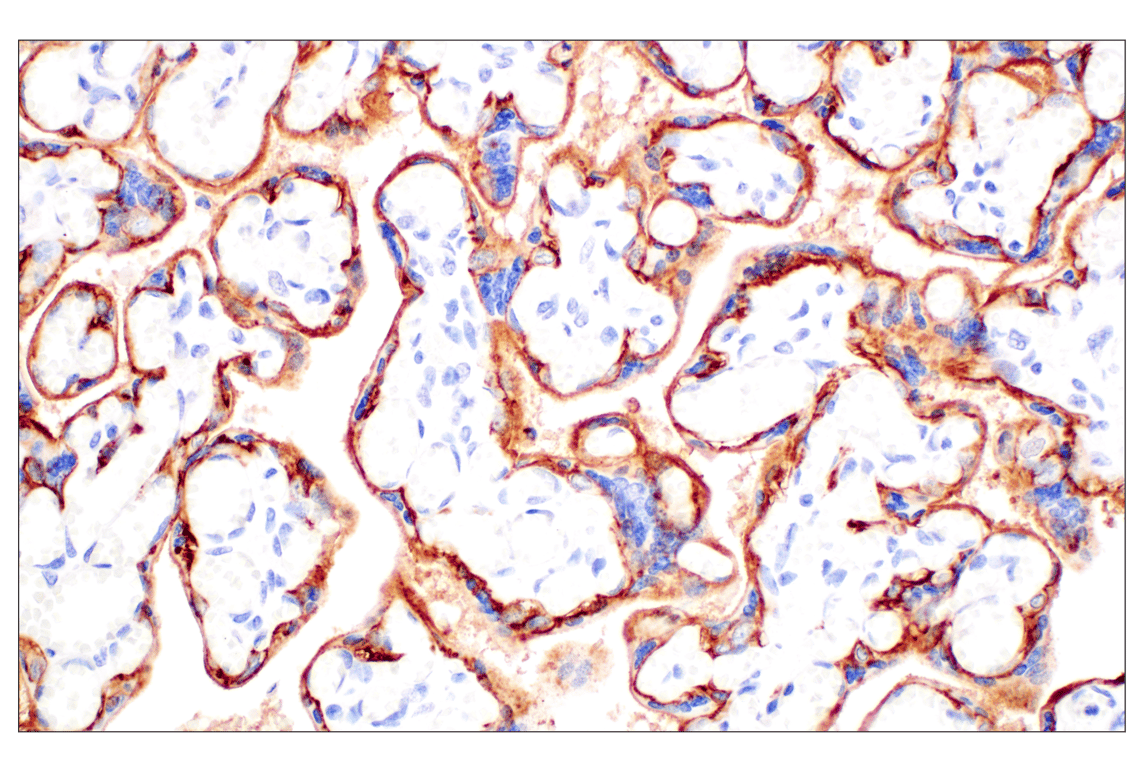
Immunohistochemistry Image 7: TACSTD2/TROP2 (F4W4J) Rabbit Monoclonal Antibody (BSA and Azide Free)

Revision 1
#88163
Store at -20C
877-616-CELL (2355)
877-678-TECH (8324)
3 Trask Lane | Danvers | Massachusetts | 01923 | USA
For Research Use Only. Not for Use in Diagnostic Procedures.
Applications:
W, IHC-Bond, IHC-P
Reactivity:
H
Sensitivity:
Endogenous
MW (kDa):
45-65
Source/Isotype:
Rabbit IgG
UniProt ID:
#P09758
Entrez-Gene Id:
4070
Product Usage Information
This formulation is ideal for use with technologies requiring specialized or custom antibody labeling, including fluorophores, metals, lanthanides, and oligonucleotides. It is not recommended for ChIP, ChIP-seq, CUT&RUN or CUT&Tag assays. If you require a carrier free formulation for chromatin profiling, please contact us. Optimal dilutions/concentrations should be determined by the end user.
BSA and Azide Free antibodies are quality control tested by size exclusion chromatography (SEC) to determine antibody integrity.
Formulation
For standard formulation of this product see product #76730
Storage
Specificity/Sensitivity
Source / Purification
Background
Background References
- McDougall, A.R. et al. (2015) Dev Dyn 244, 99-109.
- Shvartsur, A. and Bonavida, B. (2015) Genes Cancer 6, 84-105.
- El Sewedy, T. et al. (1998) Int J Cancer 75, 324-30.
- Linnenbach, A.J. et al. (1993) Mol Cell Biol 13, 1507-15.
- Trerotola, M. et al. (2013) Cancer Res 73, 3155-67.
- Trerotola, M. et al. (2015) Oncotarget 6, 14318-28.
- Nakatsukasa, M. et al. (2010) Am J Pathol 177, 1344-55.
- Cubas, R. et al. (2010) Mol Cancer 9, 253.
- Pavšič, M. et al. (2015) Sci Rep 5, 10324.
- Stoyanova, T. et al. (2012) Genes Dev 26, 2271-85.
- Ju, X. et al. (2016) Cancer Res 76, 6723-34.
Species Reactivity
Species reactivity is determined by testing in at least one approved application (e.g., western blot).
Applications Key
W: Western Blotting IHC-Bond: IHC Leica Bond IHC-P: Immunohistochemistry (Paraffin)
Cross-Reactivity Key
H: Human
Trademarks and Patents
Cell Signaling Technology is a trademark of Cell Signaling Technology, Inc.
All other trademarks are the property of their respective owners. Visit cellsignal.com/trademarks for more information.
Limited Uses
Except as otherwise expressly agreed in a writing signed by a legally authorized representative of CST, the following terms apply to Products provided by CST, its affiliates or its distributors. Any Customer's terms and conditions that are in addition to, or different from, those contained herein, unless separately accepted in writing by a legally authorized representative of CST, are rejected and are of no force or effect.
Products are labeled with For Research Use Only or a similar labeling statement and have not been approved, cleared, or licensed by the FDA or other regulatory foreign or domestic entity, for any purpose. Customer shall not use any Product for any diagnostic or therapeutic purpose, or otherwise in any manner that conflicts with its labeling statement. Products sold or licensed by CST are provided for Customer as the end-user and solely for research and development uses. Any use of Product for diagnostic, prophylactic or therapeutic purposes, or any purchase of Product for resale (alone or as a component) or other commercial purpose, requires a separate license from CST. Customer shall (a) not sell, license, loan, donate or otherwise transfer or make available any Product to any third party, whether alone or in combination with other materials, or use the Products to manufacture any commercial products, (b) not copy, modify, reverse engineer, decompile, disassemble or otherwise attempt to discover the underlying structure or technology of the Products, or use the Products for the purpose of developing any products or services that would compete with CST products or services, (c) not alter or remove from the Products any trademarks, trade names, logos, patent or copyright notices or markings, (d) use the Products solely in accordance with CST Product Terms of Sale and any applicable documentation, and (e) comply with any license, terms of service or similar agreement with respect to any third party products or services used by Customer in connection with the Products.
Revision 1



Revision 1

Revision 1

Revision 1

Revision 1



Revision 1
